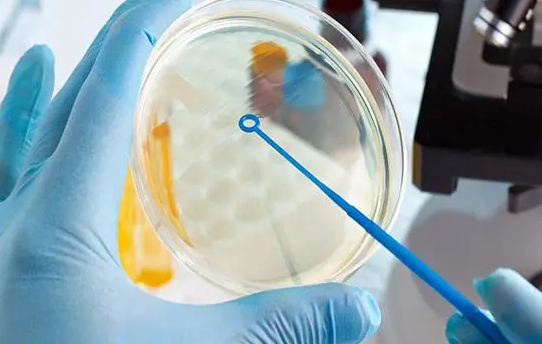

单角子宫女性做三代试管着床困难一般移植几个胚胎比较好?
问题描述: 由于我是单角子宫,所以受孕一直都是比较困难的,后面和家里人商量好以后,就直接去做了三代试管,医生在做完身体评估以后,说我的情况着床比较困难,要好好想想移植几个胚胎比较好,我最近也在网上查阅相关的资料,可是还是一无所获,就想着问问大家,具体多少个好一些?
慈医生
肺炎、肠炎、新生儿黄疸、溶血、早产儿、缺氧缺血性脑病
单角子宫试管一般移植1-2个胚胎,不宜移植过多。单角子宫的宫腔容积相对较小,若移植过多胚胎,不仅可能导致胚胎着床困难,还会增加孕期并发症的风险,如早产、流产、妊娠期高血压等。因此,为确保母婴安全,提高试管婴儿成功率,医生通常会建议患者移植适量胚胎,避免过多移植带来的潜在风险。
对于单角子宫患者来说,虽然能够通过试管技术很好解决生育的问题。但是在移植过程中,由于子宫结构的特殊性,胚胎移植的数量需要更加谨慎地考虑。通常医生会建议移植1-2个胚胎,因为移植多个的话,可能对身体造成一定的影响。
1、胎着床困难
在有限的宫腔容积内,多个胚胎的着床位置可能不理想,导致着床失败或胚胎发育异常。此外,过多的胚胎还可能产生过多的激素和代谢产物,对母体造成一定的负担,进而影响胚胎的正常发育。
2、容易流产
单角子宫由于宫腔容积有限,无法为多个胚胎提供足够的生长空间,因此多胎妊娠时,胚胎之间的竞争会加剧,导致营养和氧气供应不足,进而增加流产和早产的风险。
3、加并发症风险
随着胚胎数量的增加,孕妇的身体负担也会相应加重,容易出现高血压、糖尿病等妊娠期疾病。这些疾病不仅会影响孕妇的健康,还可能对胎儿的生长发育造成不良影响,甚至导致胎儿畸形或死亡。
综上所述,单角子宫试管移植过多胚胎会造成一系列不好的影响,因此,在进行试管婴儿移植时,医生应根据患者的具体情况,科学合理地选择移植的胚胎数量,避免过多移植带来的潜在风险。同时,患者也应充分了解移植过多胚胎可能带来的不良后果,积极配合医生的治疗。
特别声明:
1、本文由天韵赐禧整理发布,未经许可禁止转载、抄袭及引用,本文永久地址:http://www.dfivf.com//ask/14597.html
2、本站所有内容均不能代替医生的当面诊断,内容仅供参考,请在专业医师指导下操作,本站不承担由此引起的任何责任。
相关推荐
RELATE-
三代试管长方案取10个卵泡7个不成熟是怎么回事?
我们夫妻两个结婚以后就开始要孩子了,什么方法都试过了,还是没有成功。于是就决定去做三代试管,我选择的是长方案促排,前天医院那边就给我安排了取卵手术,一共取出来了10个卵泡,但是今天却电话话告诉我,其中有7个不成熟,想问问大家这是怎么回事?
何医生
-
多囊患者做三代试管促排治疗后只有3个成熟卵泡正常吗?
我在尝试多次自然受孕无果的情况下,选择去做了三代试管婴儿,我本身就是多囊卵巢综合征患者,在进行促排治疗之后,最后只有3个成熟的卵泡,我之前听说我这种情况一般取的卵泡数量会比较多,心里有点想不明白,想问问这个正常吗?
#多囊
丁医生
-
30岁女性CA125偏高一点能做三代试管促排卵吗?
我的今年30岁了,卵子质量和数量都不太行,所以一直都没有要孩子,,在看了医生以后,都建议我去做三代试管婴儿促排卵,本来我已经和老公商量好了再下一个月去做,但是今天上午的时候,医院给我打电话说我之前做的体检报告下来了,发现CA125偏高一点,这简直就是晴天霹雳啊,想问问大家我还能去做试管吗?
胡医生